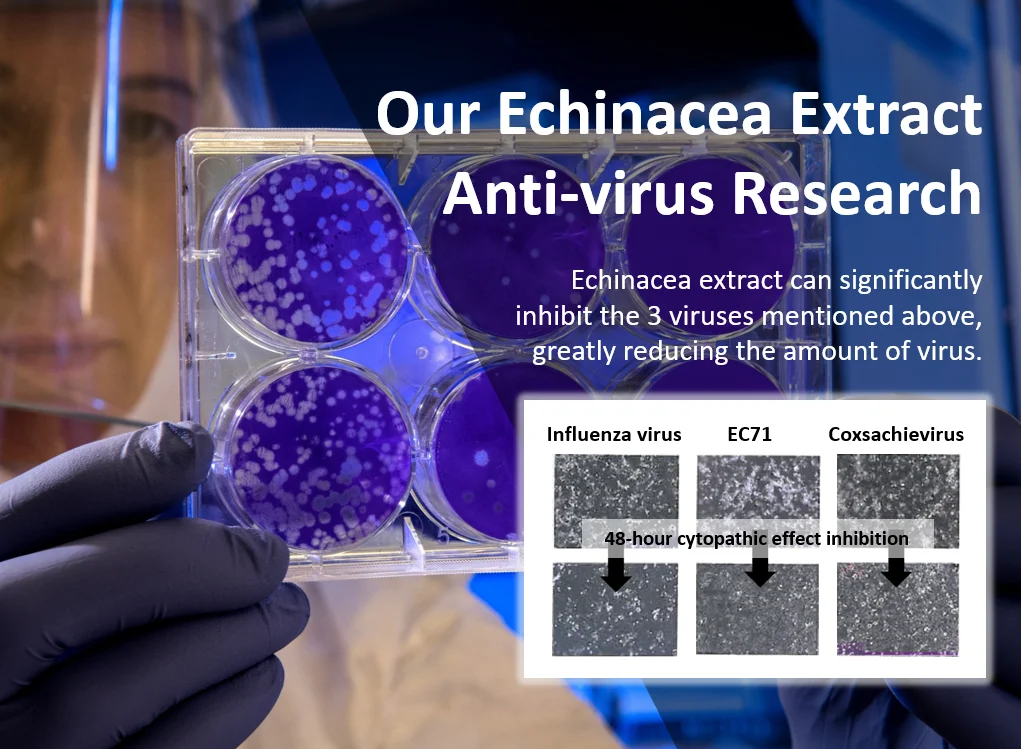
5.png

Flothy Echinacea flower extract Oral Liquid Regulate immunity tonic drink
- Category: >>>
- Supplier: TAIWAN DIRECT BIOTECHNOLOGY CORP.
Share on (62464186349):
Product Overview
Description
Product Description
| Function | Regulate immunity |
| Type | Functional Drink |
| Place of Origin | Taiwan, China |
| Brand Name | Private Label |
| Product Name | Echinaeca Tonic drink |
| Dosage Form | Oral Liquid |
| Main Ingredient | Echinacea flower extrac,elderberry, vitamin C,B-cyclodextrin,Sambucus |
| Service | ODM Private Label |
We Recommend
New Arrivals
New products from manufacturers at wholesale prices